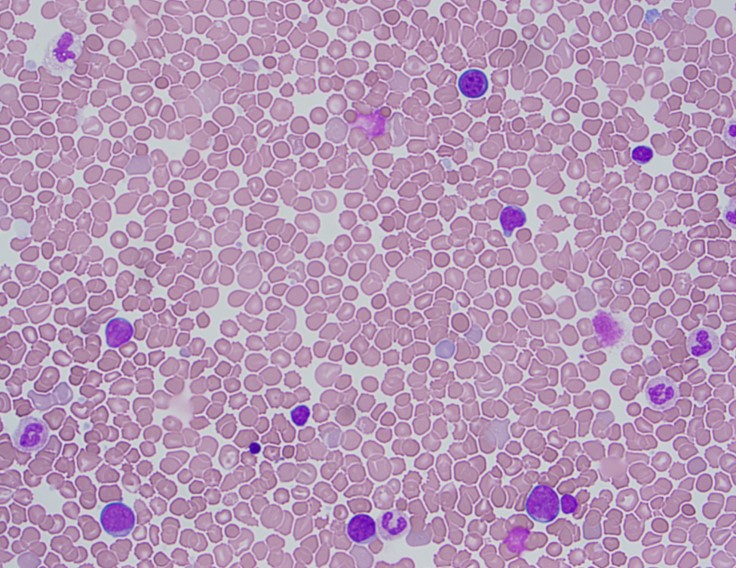
TAM1.jpg
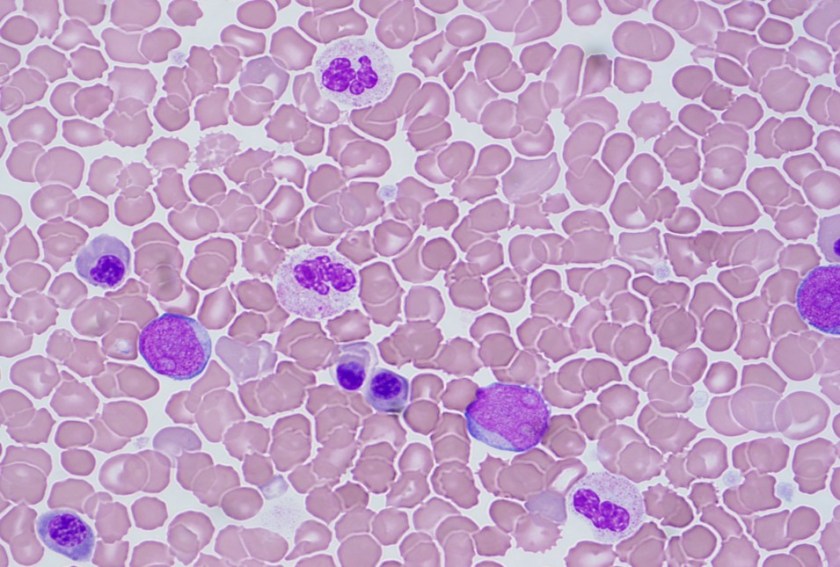
TAM2

Case History
The patient is a 1 day old baby boy born at 39 weeks to a 44 year old woman. On physical examination, the baby had a mildly flattened occiput with thickened nuchal skin, downward slant of palpebral fissures with epichanthal folds and slightly low set ears. On imaging, he had a ventricular septal defect. A CBC was performed which revealed a white count of 34.2 K/uL with a differential that included 37 blasts.
Peripheral Blood Smear

Cytogenetics


Diagnosis
The peripheral blood showed an increased white count, many nucleated red blood cells as well as a population of blasts. The cytogenetic analysis confirmed the suspicion of trisomy 21. Flow cytometry showed that the population of blasts expressed myeloid as well as erythroid and megakaryocytic lineage specific antigens. The patient was found to have a GATA1 mutation. Approximately one month after birth, the patient’s white count normalized to 7.2 K/uL with only 4 circulating blasts counted.
Discussion
In a patient with trisomy 21, this presentation is consistent with a diagnosis of transient abnormal myelopoiesis associated with Down syndrome (TAM). TAM occurs in 10% of newborns with Down syndrome. Patients typically present with cytopenias, leukocytosis, an increase in blasts and hepatosplenomegaly. Less commonly, patients can have respiratory distress, bleeding, skin rash or jaundice. The blasts are morphologically and immunophenotypically similar to those seen in acute myeloid leukemia. They often have basophilic cytoplasm, coarse basophilic granules and cytoplasmic blebbing, which suggests a megakaryocytic lineage. The immunophenotype generally includes expression of myeloid markers such as CD117, CD13 and CD33 plus erythroid and megakaryocytic markers like CD41, CD42b and CD61.1
In addition to trisomy 21, mutations in GATA1 are almost always seen in the blast cells of patients with TAM. GATA1 is a hematopoetic transcription factor. Bhatnagar, et al. (see diagram below) describe a three step model to explain the evolution of TAM. The initial event is abnormal hematopoesis in the fetal liver caused by trisomy 21. This causes an increase in megakaryocyte-erythroid progenitors in the hematopoetic stem cell compartment. The second step is the acquisition of an N-terminal truncating GATA1 mutation before birth. GATA1 is a regulator of normal megakaryocyte and erythroid differentiation. The truncated mutation causes marked expansion of megakaryoblastic progenitors.
TAM has a high rate of spontaneous remission and typically resolves spontaneously in 90% of patients over several weeks to 6 months. This coincides with extinction of the GATA1 clone. However, in around 10% of these patients, myeloid leukemia of Down syndrome (ML-DS) develops within 5 years of the initial presentation. Additional mutations in cohesion component genes and epigenetic regulators occur in these patients that result in clonal expansion and non-transient leukemia. 2 Children who develop ML-DS generally have a good response to chemotherapy and a have a better prognosis than children without Down syndrome who develop AML.
References
- Swerdlow SH, Campo E, Harris NL, et al. WHO Classification of Tumours of Haematopoetic and Lymphoid Tissues (Revised 4th edition). IARC: Lyon 2017.
- Bhatnagar, Neha et al. “Transient Abnormal Myelopoiesis and AML in Down Syndrome: An Update.” Current Hematologic Malignancy Reports5 (2016): 333–341. PMC. Web. 21 Oct. 2018.

–Chelsea Marcus, MD is a third year resident in anatomic and clinical pathology at Beth Israel Deaconess Medical Center in Boston, MA and will be starting her fellowship in Hematopathology at BIDMC in July. She has a particular interest in High-grade B-Cell lymphomas and the genetic alterations of these lymphomas.